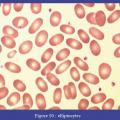

Tumeurs du sein - Petit sein densité de type 4
TUMEURS DU SEIN
DENSITE MAMMAIRE
MAMMOGRAPHIE
Image
Tumeurs du sein - Ganglions sentinelles ex vivo
TUMEURS DU SEIN
Image
Tumeurs du sein - Microcalcifications diffuses et bilaterales, non evolutives
TUMEURS DU SEIN
MAMMOGRAPHIE
Image
Pachyméningite sustentorielle
MENINGITE
Image
Scanner cérébral normal
TOMODENSITOMETRIE
CERVEAU
Image
Aortite, artérite a cellules géantes
AORTITE
ARTERITE A CELLULES GEANTES
Image
Image
Gonarthrose fémoro-tibiale
GONARTHROSE
Image
Ostéophytose du genou gauche
GENOU
GONALGIE
Image
Arthrose digitale
ARTHROSE
Image
Elliptocytes
ERYTHROCYTES ANORMAUX
Image
Condylome acuminé
CONDYLOMES ACUMINES
PAPILLOMAVIRIDAE
Image
Cylindrome
CARCINOME ADENOIDE KYSTIQUE
Image
Syphilis primaire – chancre
CHANCRE SYPHILITIQUE
Image
Ophtalmoplégie internucléaire
OPHTALMOPLEGIE
SCLEROSE EN PLAQUES
Image
IRM cérébrale, coupe axiale en séquence T1 avec injection de gadolinium
IRM
IMAGERIE PAR RESONANCE MAGNETIQUE
GADOLINIUM
Image
Grossesse intra-utérine
ECHOGRAPHIE
GROSSESSE
Image
Apoplexie pituitaire (IRM cérébrale, coupe sagittale)
APOPLEXIE HYPOPHYSAIRE
SINUS CAVERNEUX
IMAGERIE PAR RESONANCE MAGNETIQUE
Image
Exotropie de l’œil droit
EXOTROPIE
OPHTALMOPLEGIE
Image
Hématome du psoas
HEMATOME DU PSOAS
Image
Occlusion digestive tumorale
TUMEURS COLORECTALES
Image
Volvulus du cæcum sur un abdomen sans préparation
ADULTE
OCCLUSION INTESTINALE
Image
Pouce à ressaut droit
DOIGT A RESSAUT
Image
Maladie de Dupuytren
MALADIE DE DUPUYTREN
Image
Luxation du pouce
TRAUMATISMES DU DOIGT
Image